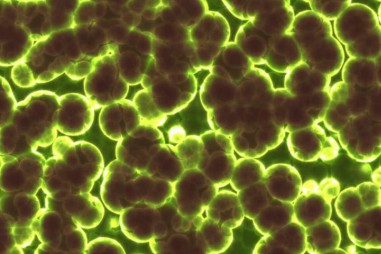
Thử nghiệm thuốc điều trị trầm cảm từ nấm ma thuật

15:10 - 15/03/2021
Việt Nam kỳ vọng xuất khẩu vắc xin Covivac năm 2022
TNNN - Sáng nay (15/3), Đại học Y Hà Nội và Viện Vệ sinh Dịch tễ Trung ương bắt đầu thử nghiệm lâm sàng giai đoạn 1 vắc xin Covivac trên 6 tình...

TNNN - Sáng nay (15/3), Đại học Y Hà Nội và Viện Vệ sinh Dịch tễ Trung ương bắt đầu thử nghiệm lâm sàng giai đoạn 1 vắc xin Covivac trên 6 tình...

TNNN - Sáng 14/1, Học viện Quân y bắt đầu tiêm mũi 2 vắc xin Nanocovax liều 25mcg cho 3 tình nguyện viên đầu tiên của nhóm 1 (gồm 20 người) sau 28...

TNNN - Ba tình nguyện viên gồm 2 nam, 1 nữ, tuổi 18-50 đã được tiêm mũi vaccine Nanocovax đầu tiên vào sáng 17/12/2020. Danh tính của họ được bảo mật.

TNNN - Hưởng ứng phong trào chung tay góp sức, đồng lòng cùng cả nước phòng chống dịch bệnh Covid-19, Chi đoàn Thanh niên Công ty Cổ phần Chứng nhận...
TNNN - Nhóm các nhà nghiên cứu từ Đại học King, London hợp tác với công ty Compass Pathways đã công bố kết quả thử nghiệm lâm sàng Giai đoạn 1 thuốc...